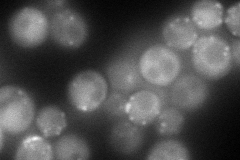
YOR367W
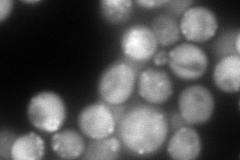
YOR367W
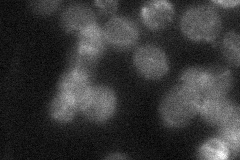
YOR367W
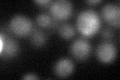
YOR367W
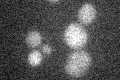
YOR367W

View description
Component of yeast cortical actin cytoskeleton, binds and cross links actin filaments; originally identified by its homology to calponin (contains a calponin-like repeat) but the Scp1p domain structure is more similar to transgelin
Localization:
Intensity:
Fold change:
Significance:
-
C’ GFP library in SD

below threshold13.5 -
N' NOP1pr-GFP in SD
cytosol,punctate124.278 -
N' TEF2pr-mCherry in SD
punctate,bud neck210.795 -
N' NATIVEpr-GFP in SD
punctate,bud neck21.9503 -
N' TEF2pr-VC and Cyto-VN in SD

#N/A0 -
C’ GFP library in SD+DTT
cytosol15.961.18No -
C’ GFP library in SD+H2O2

cytosol17.551.3No -
C’ GFP library in Starvation Media
cytosol17.071.26No -
C’ GFP library on the background of Pup2-DaMP

below threshold -
C’ GFP library on the background of CCT mutant

below threshold15.97191.1828No
